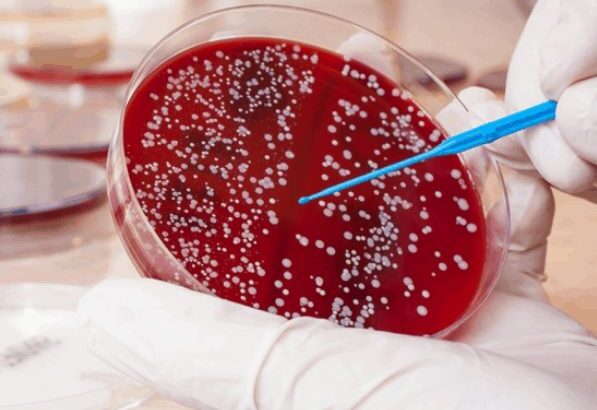

Các nhà khoa học thuộc Đại học South Australia cho biết đang đạt tiến triển về một phương pháp điều trị mới bệnh ung thư máu.
Theo kết quả nghiên cứu được công bố ngày 26/6, các nhà nghiên cứu đã phát hiện rằng tế bào bạch cầu gọi là đại thực bào có vai trò quan trọng trong quá trình phát triển bệnh đa u tủy xương, một loại ung thư máu thường gặp ở những người trên 60 tuổi.
Trong một cuộc thử nghiệm, nhóm nghiên cứu của do nhà khoa học Khatora Opperman dẫn đầu, đã loại bỏ các đại thực bào và điều này dẫn tới sự thu nhỏ đáng kể kích cỡ các khối u. Do vai trò quan trọng của các đại thực bào trong hệ miễn dịch, các nhà khoa học không thể loại bỏ hoặc giảm bớt lượng tế bào này ở những người mắc bệnh đa u tủy.

Trưởng nhóm nghiên cứu Khatora Opperman cho hay phát hiện này đã mở ra hướng đi mới trong việc điều trị bệnh ung thư huyết học. Bà Opperman nhận định các phương pháp điều trị hiện nay thường nhằm vào các tế bào u tủy, song với khám phá mới trên, các nhà khoa học có thể tìm cách tấn công và ngăn chặn những tế bào hỗ trợ cho các tế bào gây bệnh.
Thống kê cho thấy có khoảng 1.800 trường hợp bị chẩn đoán mắc bệnh đa u tủy tại Úc mỗi năm. Hầu như những người mắc bệnh này là trên 40 tuổi.
Theo TTXVN

No comments.
You can be the first one to leave a comment.